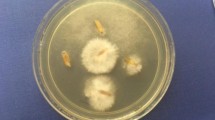

Abstract
In India more than 60 % of the population relies on crops for their livelihood. However, crop diseases are one of the major factors limiting productivity. Hence, nanotechnology appears as a new means to control diseases and enhance yield. Here, stable copper nanoparticles were synthesized using cetyl trimethyl ammonium bromide and copper nitrate at room temperature, then characterized by UV–Visible spectrophotometry, X-ray diffraction, Fourier transform infrared spectroscopy, transmission electron microscopy and zeta potential measurement. The antifungal activity was evaluated against three common crop pathogenic Fusarium spp. We found that stable copper nanoparticles synthesized using 0.030 M cetyl trimethyl ammonium bromide and 0.003 M copper nitrate have the maximum activity against Fusarium equiseti with a 25 mm zone of inhibition, followed by F. oxysporum (20 mm) and F. culmorum (19 mm).
Similar content being viewed by others
Explore related subjects
Discover the latest articles, news and stories from top researchers in related subjects.Avoid common mistakes on your manuscript.
Introduction
Currently, the most imperative challenges faced by global agriculture include changing climate, urbanization, sustainable use of natural resources, environmental issues like accumulation of pesticides and fertilizers, and increasing resistance of fungal pathogens to fungicides (Hobbelen et al. 2014). For effective and economical crop production, the knowledge on different aspects of agriculture such as pest, disease and agronomic practices is required. Developing improved systems for monitoring ecological conditions and delivering nutrients or pesticides, nanotechnology can advance our perceptive of the biology of various crops, and therefore, potentially improve production or nutritional standards. It is estimated that every year around one-third of the worldwide plant harvest is lost because of many plant pathogenic diseases and insect injuries. Besides bacterial and viral pathogens, fungal plant pathogens are the main players that contribute to the severe loss of yield. Fungi cause enormous economic loss to agriculture, loss of food for consumption and serious often fatal diseases in humans and animals. Molds and microscopic fungi have a great capacity to colonize various kinds of substrates and to propagate under extreme environmental conditions (Warzecha et al. 2011).
In the recent years, chemicals such as herbicides, pesticides and fungicides have been used extensively being cheapest way to control pests and diseases. Moreover, at present biological control methods are very expensive and time-consuming. Uncontrolled use of pesticides has caused many problems like adverse effects on human health, pollinating insects and domestic animals, also entering this material into the soil and water and its direct and indirect effect on ecosystems. Singh et al. (2013) reviewed the toxicity issues of chromium, which is a most common heavy metal contaminant in the environment, and its tolerance in the plants. Intelligent use of chemicals at nanoscale can be a suitable solution to overcome this problem. These nanomaterials are used into the part of plant, which is attacked by disease or pest. Also, these carriers in nanoscale have self-regulation, i.e., the medication on the requisite amount only be delivered into plant tissue. Nanotechnology helps agriculture science and reduces environmental pollution generated due to excessive use of chemical fertilizers and pesticides. The nanoparticles and nanocapsules with the capability to manage or delayed delivery, and fabrication of nanocrystals to augment the efficiency of pesticides for application with lower dose are important (Mousavi and Rezaei 2011).
The application of nanoparticles in various fields has a greater impact on the society as well as on the world economy. The copper metals were absorbed efficiently in a continuous flow mode from polluted water by application of alginate immobilized water hyacinth, i.e., Eichhornia crassipes, which acts as a promising biosorbent in an acidic environment (Mahamadi and Zambara 2013). Similarly, Kasiri and Safapour (2014) in a review on natural dyes and antimicrobials for green treatments of textiles have discussed about extraction methods of natural dyes or antimicrobials and their use in textile treatments. Hu et al. (2014) demonstrated the heavy metal entrapment by chemical immobilization technique, which is promising for the soil heavy metal contamination due to their major concern with the health. The application of coal fly ash and straw to the soil sample following the incubation of 6 weeks and the measurement of CaCl2 extractable, copper, cadmium, zinc, phytoavailability and soil microbial activity were studied. The authors reported that the coal fly ash and its mixture stabilizes these metals efficiently.
Different Fusarium spp. such as Fusarium culmorum, F. oxysporum and F. equiseti. F. culmorum cause preemergence seedling blight, root rot and foot rot and head blight in barley and wheat (Bottalico 1998; Prom et al. 1999; Clear and Patrick 2000; Mesterhazy et al. 2005), brown patch of turf, foot rot of carnation, asparagus, pea and leek, storage rots of apple, potato, sugar beet, bulbs (Booth and Waterson 1964), ear blight and stalk rot. F. oxysporum infects spinach, lettuce, potato, tomato, sugarcane, garden pea, cowpea, prickly pear, cultivated zinnia, pansy and Assam rattlebox (Raabe et al. 1981) and causes plant diseases such as, chickpea wilt, black point disease, Fusarium head blight, vascular wilt, yellows, Fusarium crown, corm rot, root rot and damping off. F. equiseti is a soil dweller and can infect seeds, roots, tubers and fruits of several crop plants. It is causal agent of disease on diverse crop plants, such as cotton, cowpea, lentils, sugar beet, potato and pine.
Considering the above issues, huge loss in yield of crop, there is need for the development of new fungicidal agent.
The aim of the present study was to synthesize stable copper nanoparticles using chemical method and evaluation of its antifungal activity against above three crop pathogenic fungi.
Materials and methods
Materials
Cetyl trimethyl ammonium bromide, copper(II) nitrate (Cu (NO3)2·3H2O) solution and isopropyl alcohol were used as it is without further purification as starting materials.
Synthesis of copper nanoparticles by chemical method
The copper nanoparticles were synthesized using cetyl trimethyl ammonium bromide method (Kanhed et al. 2014). The method was optimized for the optimum concentration of cetyl trimethyl ammonium bromide and copper nitrate with respect to the stability of the nanoparticles. For the optimization study, the cetyl trimethyl ammonium bromide concentration range considered was 0.010–0.100 M and for copper nitrate the range of concentration studied was 0.0010–0.0100 M. At room temperature, 20 ml copper nitrate solution of different concentration (0.0010–0.0100 M) and 20 ml of cetyl trimethyl ammonium bromide solution of different concentration (0.010–0.100 M) were prepared in isopropyl alcohol. The copper nitrate solution was then added drop wise (about 1 drop/second) to cetyl trimethyl ammonium bromide solution with vigorous stirring on magnetic stirrer in a conical flask. The change in color of the solution was observed.
Characterization of copper nanoparticles
The synthesized copper nanoparticles were characterized by UV–Visible spectrophotometer, X-ray diffraction technique, Fourier transform infrared spectroscopy, transmission electron micrograph analysis and zeta potential measurement. Primary detection of copper nanoparticles was done visually by color change of solution. The absorbance of nanoparticles solution was recorded using UV–Visible spectrophotometer (Shimadzu UV-1700, Japan). The spectrum was scanned in the range of 200–800 nm. The nanoparticles exhibit strong absorbance in the visible range due to the surface plasmon resonance phenomenon. The size and shape of copper nanoparticles were determined by transmission electron microscope (Philips, CM 12) on conventional carbon-coated copper grid (400 meshes, Plano Gmbh, Germany). The crystalline nature of metallic copper nanoparticles was confirmed by selected area electron diffraction pattern. The formation of copper nanoparticles was confirmed by X-ray diffraction analysis. The X-ray diffraction pattern of copper nanoparticles was recorded by using a diffractometer (Bruker, D8) with Cu Kα radiation (λ = 1.5408 Å). The powder of copper nanoparticles for X-ray diffraction analysis was prepared and then crushed in mortar and pestle. The powdered sample was scanned from 20° to 80° of 2θ with a 46 s counting time. Using Zetasizer (Malvern ZS-90) instrument, zeta potential, i.e. stability of copper nanoparticles, was measured. The infrared spectra were recorded on Fourier transform infrared spectrophotometer. Using dry potassium bromide as standard reference in the range of 400–4000 cm−1 gives idea about the capping and stability of nanoparticles.
Colony-forming unit/ml
This method was used to calculate the fungal load using spectrophotometer with test inoculums in the range 0.4 × 104 to 5 × 104 colony-forming unit/ml. The optical density at wavelength 530 nm required is dependent on the conidial size of the mold being tested. This method was used before the evaluation of antifungal activity (CLSI 2002).
Materials
RPMI-1640 medium (Himedia, Mumbai) with glutamine, phenol red as a pH indicator and without bicarbonate), Potato Dextrose Broth and fungal cultures F. culmorum (MTCC 349), F. oxysporum (MTCC 1755) and F. equiseti (MTCC 3731).
Methods
The fungi were inoculated in the potato dextrose broth and incubated at 25 ± 2 °C for 15 days to grow the fungal biomass. After growth of fungal biomass, potato dextrose broth was discarded from conical flask and the flask containing fungal biomass 5–10 ml of RPMI-1640 medium was added under sterile condition. Then, the conidia were allowed to suspend in medium. Optical density of above suspension was measured by using colorimeter and adjusted between 0.15 and 0.17 using RPMI-1640 medium. Then, this suspension was used for evaluation of antifungal activity.
In vitro antifungal activity of copper nanoparticles
The antifungal activity of copper nanoparticles was evaluated by Kirby–Bauer disk diffusion method against F. culmorum (MTCC 349), F. oxysporum (MTCC 1755) and F. equiseti (MTCC 3731).
Materials
Sterile disks (Himedia, Mumbai), solution of copper nanoparticles, isopropyl alcohol, copper salt solution, antifungal agent amphotericin B, fungal suspensions prepared by CLSI M38-A method and potato dextrose agar (Potato infusion—200 g, Dextrose—20 g, Agar–Agar—20 g and Distilled water—1000 ml).
Incubation
The potato dextrose agar was prepared as per standard composition and autoclaved at 121 °C at 15 lbs pressure for 15 min. Plates were prepared by pouring the potato dextrose agar and allowed to solidify. After solidification, fungal suspensions were prepared according to CLSI M38-A method and inoculated on the surface of potato dextrose agar with cotton swabs. Four different types of disks, i.e., isopropyl alcohol, copper salt, copper nanoparticles solution and antifungal disks (amphotericin B) were placed at four different places on the potato dextrose agar surface in petriplates. These plates were incubated at 28° ± 2 °C for 72 h. Zones of inhibition were measured with zone measurement scale.
Results and discussion
It is well-known property of copper nanoparticles that they oxidize easily in presence of air. This can be prevented by capping of the nanoparticles using a capping agent. The synthesis of copper nanoparticles in the present study was optimized for the use of the cetyl trimethyl ammonium bromide concentration in the range of 0.010–0.100 M and copper nitrate in the range from 0.0010 to 0.0100 M. The least concentration of copper nitrate, which could support the synthesis of copper nanoparticles was found to be 0.003 M, whereas the least concentration of cetyl trimethyl ammonium bromide which could support the synthesis of copper nanoparticles was 0.02 M. Kanhed et al. (2014) have reported the synthesis of copper nanoparticles using similar concentration of copper nitrate (0.003 M) but with higher concentration of cetyl trimethyl ammonium bromide (0.090 M). There are reports of using different concentrations of cetyl trimethyl ammonium bromide for the synthesis of copper nanoparticles like 0.087 M (Zhang and Cui 2009), 0.09 M (Bahadory 2008) and 50 % (Lee et al. 2014).The specific color change for copper nanoparticles was dark violet, which was observed after the addition of copper nitrate in the cetyl trimethyl ammonium bromide solution with constant stirring on magnetic stirrer as shown in Fig. 1a (inset figure). The color change was because of the excitation of surface plasmon resonance of metal copper nanoparticles. Bahadory (2008) reported the similar change in color after synthesis of copper nanoparticles by chemical method .
a UV–Vis spectra of copper nanoparticles (inset violet brown colloidal solution of copper nanoparticles) showing the absorbance at 563 nm (A isopropyl alcohol, B copper salt, C copper nanoparticles), b X-ray diffraction analysis of copper nanoparticles confirms the crystal structure as face-centered cubic crystal structure with their Miller indices, c Fourier transform infrared spectra for control, peak at 3427.23 cm−1 shows the O–H stretching, peak at 2100.36 cm−1 shows C≡C stretching, sharp peak at 1640.87 cm−1 shows C=C stretching and sharp peak at 1125.22 cm−1 shows O–C stretching. d Fourier transform infrared spectra of copper nanoparticles, some stretches are similar to the stretches of control but some additional stretches are also present that are sharp peaks: those at 2850.59 and 2918.37 cm−1 show CH3, CH2 and CH stretching, the one at 1145.32 cm−1 shows C–N stretching and the one at 1734.21 cm−1 shows C=O stretching, showing vibrations of different conformational changes during synthesis
The formation of copper nanoparticles after reaction was further detected by optical measurements using UV–Vis spectrophotometer based on its characteristic surface plasmon resonance. For copper nanoparticles, spectra of the reaction samples of copper nitrate solution, isopropyl alcohol and copper nanoparticles were recorded simultaneously. Copper nanoparticles showed a typical resonance at about 563 nm (Fig. 1a). This absorbance corresponds with the results obtained in the study by Bahadory (2008) in which absorbance of copper nanoparticles was found at 560 nm.
The X-ray diffraction pattern recorded for copper nanoparticles have been shown in Fig. 1b. The X-ray diffraction peak positions were consistent with metallic copper. The sharp peaks of the X-ray diffraction pattern indicate crystalline nature of copper nanoparticles. For copper nanoparticles, the peaks at 43.31°, 50.44° and 74.12° corresponding to the Miller indices (111), (200) and (220), respectively, represent face-centered cubic crystal structure of copper. The X-ray diffraction results confirm the presence of copper nanoparticles by chemical method. The X-ray diffraction peak positions corroborate with the results obtained for copper nanoparticles by Ramyadevi et al. (2012).
Figure 1c, d represents Fourier transform infrared spectral analysis in which the spectra of control and copper nanoparticles were compared with each other for the presence of capping agent. In spectra of control, peak at 3427.23 cm−1 shows the O–H stretching, peak at 2100.36 cm−1 shows C≡C stretching, sharp peak at 1640.87 cm−1 shows C=C stretching and sharp peak at 1125.22 cm−1 shows O–C stretching. In spectra of copper nanoparticles, some stretches are similar to the stretches of control but some additional stretches are also present that are sharp peaks: those at 2850.59 and 2918.37 cm−1 show CH3, CH2 and CH stretching, the one at 1145.32 cm−1 shows C–N stretching and the one at 1734.21 cm−1 shows C=O stretching. From these evidences drawn through Fourier transform infrared spectral data, we confirm that the capping agents are present on the surface of copper nanoparticles which capped and stabilized the nanoparticles.
Transmission electron micrograph analysis of copper nanoparticles provides the actual size and shape of synthesized nanoparticles. The transmission electron micrograph showed that the copper nanoparticles were spherical in shape with variable sizes. Figure 2 shows the distribution of spherical copper nanoparticles of different size in the range of 100 nm range scale. Jang et al. (2012) reported chemically synthesized copper nanoparticles by wet method in which they found distributed spherical copper particles in the range of 50–300 nm.
Transmission electron micrograph of copper nanoparticles shows the size of nanoparticles ranging from 3 to 30 nm and selected area electron diffraction pattern inset which shows the rings around confirms the Miller indices of these nanoparticles which appears as a face-centered cubic crystal structure of copper nanoparticles
One of the drawbacks of cetyl trimethyl ammonium bromide method of copper nanoparticles synthesis was the stability (Magdassi et al. 2010; Shah et al. 2014). The zeta potential was measured for the determination of stability of copper nanoparticles. It depends on the charge behavior phenomenon. If zeta potential value is in between −30 and +30, then nanoparticles are said to be unstable. In graph, total counts represent the number of particles that passes through the beam of light. Keeping the stability aspect of the synthesized copper nanoparticles in mind, the zeta potential measurements of different concentration of cetyl trimethyl ammonium bromide and copper nitrate were recorded. The least concentration of cetyl trimethyl ammonium bromide and copper nitrate was found to be 0.02 and 0.003 M, respectively, but considering the zeta potential measurements the optimum concentration of cetyl trimethyl ammonium bromide and copper nitrate was 0.03 and 0.003 M, respectively. The highest zeta potential value was found to be +53.8 mV which represents that these nanoparticles were highly stable (Fig. 3a, b), with the concentration of 0.03 M cetyl trimethyl ammonium bromide and 0.003 M copper nitrate.
a Zeta potential values of copper nanoparticles with 0.020 M cetyl trimethyl ammonium bromide and variable copper nitrate concentration (0.0010–0.0100 M) (the highest value +51.5 mV obtained at 0.0030 M copper nitrate concentration). b Zeta potential values of copper nanoparticles with 0.0030 M copper nitrate and variable cetyl trimethyl ammonium bromide concentration (0.010–0.100 M) (the highest value +53.8 mV obtained at 0.030 M cetyl trimethyl ammonium bromide concentration)
The CLSI M38-A standard describes a method for testing antifungal susceptibility of filamentous fungi (molds) that cause invasive infections, including Aspergillus spp., Fusarium spp., Pseudallescheria (Scedosporium) spp., zygomycetes and other pathogenic molds. In the present study, CLSI M38-A method was used to count the colony-forming unit/ml, i.e. calculation of fungal load for antifungal activity using the RPMI-1640 medium. The optical density was measured at 530 nm on colorimeter, which is fixed for each filamentous fungus, i.e. for Fusarium spp. the optical density should be 0.15–0.17 which is equivalent to 0.4 × 104 to 5 × 104 colony-forming unit/ml (CLSI 2002). The optical density values for F. oxysporum, F. culmorum and F. equiseti were found to be 0.17, 0.15 and 0.17, respectively.
In vitro antifungal activity of synthesized copper nanoparticles was evaluated against three different crop pathogenic fungi, viz Fusarium c., F. oxysporum and F. equiseti. Interestingly, copper nanoparticles showed remarkable activity against these tested crop pathogenic fungi (shown in Fig. 4). For antifungal activity, amphotericin B was used as a standard antifungal agent. Copper nanoparticles have shown the maximum activity against F. equiseti, i.e. the zone of inhibition was found to be 25 mm diameter followed by F. oxysporum (20 mm) and F. culmorum (19 mm) as shown in Fig. 4. For evaluation of antifungal activity, Kirby–Bauer disk diffusion method was used (Gittard et al. 2010). The experiment was maintained in triplicate. Kanhed et al. (2014) also reported in vitro antifungal activity of chemically synthesized copper nanoparticles in combination with a commercial antifungal agent, i.e. Bavistin against four different plant pathogenic fungi, viz. F. oxysporum, C. lunata, A. alternata and P. destructiva. Copper nanoparticles showed activity against all the plant pathogenic fungi used in their experiment.
In vitro antifungal activity of copper nanoparticles against crop pathogenic fungi, viz. F. culmorum, F. oxysporum and F. equiseti as shown in graph where a copper nanoparticles, b copper salt, c isopropyl alcohol, d amphotericin B (antifungal agent); the respective antifungal activity plates also are shown below the graph (plate 1—Fusarium culmorum, plate 2—Fusarium oxysporum, plate 3—Fusarium equiseti). Copper nanoparticles show the significant and greater activity against F. equiseti, i.e. the zone of inhibition followed by F. oxysporum and then by F. culmorum. (Horizontal line in the graph represents the disk diameter 6 mm)
Conclusions
Stable copper nanoparticles can be synthesized effectively using cetyl trimethyl ammonium bromide method with lesser concentration of cetyl trimethyl ammonium bromide and method was found to be simple, economic and rapid. Cetyl trimethyl ammonium bromide molecules catalyze the reduction of Cu2+ ions to Cu0 with isopropyl alcohol and also act as a capping agent by surrounding the surface of copper nanoparticles. Thus, the formation of copper nanoparticles was confirmed by UV–Vis spectrophotometer, zeta potential analysis, transmission electron micrograph, X-ray diffraction and Fourier transform infrared spectroscopy analysis. Copper nanoparticles synthesized in the present study showed significant antifungal activity against F. oxysporum, F. culmorum and F. equiseti, which are the most common crop pathogenic fungi in Central India. Hence, these copper nanoparticles may be used as novel antifungal agent in the several nanoformulations.
References
Bahadory M (2008) Synthesis of noble metal nanoparticles. Ph. D thesis, pp 86–153
Booth C, Waterson JM (1964) Fusarium culmorum. CMI descriptions of pathogenic Fungi and Bacteria No. 26. Commonwealth Agricultural Bureaux. 2
Bottalico A (1998) Fusarium diseases of cereals: species complex and related mycotoxin profiles in Europe. J Plant Pathol 80(29):85–103
Clear RM, Patrick SK (2000) Fusarium head blight pathogens isolated from Fusarium damaged kernels of wheat in western Canada, 1993 to 1998. Can J Plant Pathol 22:51–60
CLSI (2002) Reference method for broth dilution antifungal susceptibility testing of filamentous fungi; approved standard. CLSI document M38-A. CLSI, Pennsylvania. ISBN 1-56238-470-8
Gittard SD, Hojo D, Hyde GK, Scarel G, Narayan RJ, Parsons GN (2010) Antifungal textiles formed using silver deposition in supercritical carbon dioxide. J Mater Eng Perform 19:368–373
Hobbelen PH, Paveley ND, Van Den Bosch F (2014) The emergence of resistance to fungicides. PLoS One 9(3):e91910
Hu X, Yuan X, Dong L (2014) Coal fly ash and straw immobilize Cu, Cd and Zn from mining waste land. Environ Chem Lett 12:289–295. doi:10.1007/s10311-013-0441-3
Jang KD, Ortega A, Ucol J, Du H, Kim NS (2012) Effect of lithium ions on copper nanoparticle size, shape, and distribution. J Nanotechnol 2012:1–6. doi:10.1155/2012/469834
Kanhed P, Birla S, Gaikwad S, Gade A et al (2014) In vitro antifungal efficacy of copper nanoparticles against selected crop pathogenic fungi. Mater Lett 115:13–17
Kasiri MB, Safapour S (2014) Natural dyes and antimicrobials for green treatment of textiles. Environ Chem Lett 12:1–13. doi:10.1007/s10311-013-0426-2
Lee H, Park SH, Seo S-G, Kim S-J, Kim S-C, Park Y-K, Jung S-C (2014) Preparation and characterization of copper nanoparticles via the liquid phase plasma method. Curr Nanosci 10:7–10
Magdassi S, Grouchko M, Kamyshny A (2010) Copper nanoparticles for printed electronics: routes towards achieving oxidation stability. Materials 3:4626–4638. doi:10.3390/ma3094626
Mahamadi C, Zambara P (2013) High Cu removal from water using water hyacinth fixed on alginate. Environ Chem Lett 11:377–383. doi:10.1007/s10311-013-0418-2
Mesterhazy A, Bartók T, Kászonyi G, Varga M, Tóth B, Varga J (2005) Common resistance to different Fusarium spp. causing Fusarium head blight in wheat. Eur J Plant Pathol 112:267–281
Mousavi SR, Rezaei M (2011) Nanotechnology in agriculture and food production. J Appl Environ Biol Sci 1(10):414–419
Prom LK, Horsley RD, Steffenson BJ, Schwarz PB (1999) Development of Fusarium head blight and accumulation of deoxynivalenol in barley sampled at different growth stages. J Am Soc Brew Chem 57(2):60–63
Raabe RD, Conners IL, Martinez AP (1981) Checklist of plant diseases in Hawaii: including records of microorganisms, principally fungi, found in the states. Hawaii Institute of Tropical Agriculture and Human Resources (CTAHR), information text series 022
Ramyadevi J, Jeyasubramanian K, Marikani A, Rajakumar G, Rahuman AA (2012) Synthesis and antimicrobial activity of copper nanoparticles. Mater Lett 71:114–116
Shah AT, Ahmad S, Kashif M, Khan MF, Shahzad K, Tabassum S, Mujahid A (2014) In situ synthesis of copper nanoparticles on SBA-16 silica spheres. Arab J Chem. doi:10.1016/j.arabjc.2014.02.013
Singh HP, Mahajan P, Kaur S, Batish DR, Kohli RK (2013) Chromium toxicity and tolerance in plants. Environ Chem Lett 11:229–254. doi:10.1007/s10311-013-0407-5
Warzecha T, Lundh D, Mandal A (2011) Effect of Fusarium culmorum infection on survivability of a T-DNA tagged mutant of Arabidopsis thaliana harboring a mutation in the peptide transporter gene At5g46050. J Biotechnol Comput Biol Bionanotechnol 92(1):77–84
Zhang X, Cui Z (2009) Synthesis of Cu nanowires via solventhermal reduction in reverse microemulsion system. J Phys Confer Ser 152:012022. doi:10.1088/1742-6596/152/1/012022
Acknowledgments
The authors are thankful to University Grants commission, New Delhi for financial support under UGC-SAP.
Author information
Authors and Affiliations
Corresponding author
Rights and permissions
About this article
Cite this article
Bramhanwade, K., Shende, S., Bonde, S. et al. Fungicidal activity of Cu nanoparticles against Fusarium causing crop diseases. Environ Chem Lett 14, 229–235 (2016). https://doi.org/10.1007/s10311-015-0543-1
Received:
Accepted:
Published:
Issue Date:
DOI: https://doi.org/10.1007/s10311-015-0543-1